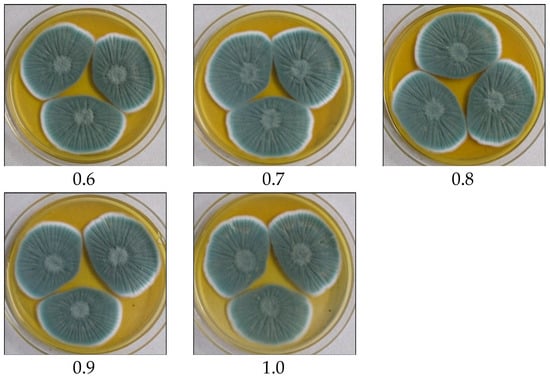

Abstract
Beta (β)-lactam antibiotic is an industrially important molecule produced by Penicillium chrysogenum/rubens. Penicillin is a building block for 6-aminopenicillanic acid (6-APA), an important active pharmaceutical intermediate (API) used for semi-synthetic antibiotics biosynthesis. In this investigation, we isolated and identified Penicillium chrysogenum, P. rubens, P. brocae, P. citrinum, Aspergillus fumigatus, A. sydowii, Talaromyces tratensis, Scopulariopsis brevicaulis, P. oxalicum, and P. dipodomyicola using the internal transcribed spacer (ITS) region and the β-tubulin (BenA) gene for precise species identification from Indian origin. Furthermore, the BenA gene distinguished between complex species of P. chrysogenum and P. rubens to a certain extent which partially failed by the ITS region. In addition, these species were distinguished by metabolic markers profiled by liquid chromatography–high resolution mass spectrometry (LC-HRMS). Secalonic acid, Meleagrin, and Roquefortine C were absent in P. rubens. The crude extract evaluated for PenV production by antibacterial activities by well diffusion method against Staphylococcus aureus NCIM-2079. A high-performance liquid chromatography (HPLC) method was developed for simultaneous detection of 6-APA, phenoxymethyl penicillin (PenV), and phenoxyacetic acid (POA). The pivotal objective was the development of an indigenous strain portfolio for PenV production. Here, a library of 80 strains of P. chrysogenum/rubens was screened for PenV production. Results showed 28 strains capable of producing PenV in a range from 10 to 120 mg/L when 80 strains were screened for its production. In addition, fermentation parameters, precursor concentration, incubation period, inoculum size, pH, and temperature were monitored for the improved PenV production using promising P. rubens strain BIONCL P45. In conclusion, P. chrysogenum/rubens strains can be explored for the industrial-scale PenV production.
1. Introduction
Fungi are the diverse group of eukaryotic organisms ubiquitous in nature []. The genus Aspergillus, Fusarium, and Penicillium find applications in various fields including food, agricultural, and pharmaceutical industries []. The Penicillium genus is a filamentous fungus comprising more than 350 species that produce various industrially important molecules such as penicillin, griseofulvin, mycophenolic acid, andrastin A, cephalosporins, chrysogine viridicatol, kojic acid sorbicillin, meleagrin, roquefortine C, xanthocillin, secalonic acid D, F, lumpidin, compactin, gibberellins, and indoleacetic acid [,,,,,,,].
Precise microorganism identification is crucial in natural product research. However, understanding fungi is a challenging task which solely relies on macromorphological and micromorphological approaches which may result in incorrect identifications []. Multigene approaches are necessary for accurate identifications at the species and strain levels [,]. Although the internal transcribed spacer (ITS) region of rDNA has been recommended as an official molecular marker for most fungal classification [,], it has failed to distinguish closely related species and clades []. Due to their impediments, β-tubulin (BenA) and translational elongation factor 1α (TEF-1α) are the recognized molecular markers for species-level identification of Penicillium and Fusarium species, respectively, that can segregate the closely related species.
Penicillin was a breakthrough drug in medical history produced by P. chrysogenum/rubens species. Benzylpenicillin (Penicillin G; PenG) and phenoxymethyl penicillin (Penicillin V; PenV). Natural penicillins display excellent activity against both Gram-positive and selected Gram-negative bacteria []. Natural penicillins are the substrate for 6-amino penicillanic acid (6-APA) by penicillin acylases, which is important to produce semisynthetic β-lactam antibiotics. Global demand for semisynthetic β-lactam antibiotics is 6000 metric tons per year, accounting for approximately 65% of the total antibiotic market [,]. PenV is formed when Phenoxy acetic acid (POA) is added into a fermentation medium along with a highly stable at acidic pH, whereas PenG is less stable. Hence, it can be used in oral demonstrations to treat especially, strep throat, otitis, and cellulitis, and helps in preventing rheumatic fever []. Widespread uses of these β-lactam antibiotics lead to antimicrobial resistance (AMR) globally. AMR is a sign of serious threat to public health which forced researchers to ascertain new and amended antibiotics []. Pharmaceutical production and trade have been disrupted during the COVID-19 pandemic in many countries worldwide. In consequence, the use of precise antibiotic for infections is necessary for curing infection and reducing AMR. Hence, domestic production of antibiotics/medicines/Active Pharmaceutical Intermediates (APIs) is necessary to replace the bulk of these APIs.
We have explored the preparation of an indigenous P. rubens strain portfolio for industrial scale PenG/V production. In this study, we isolated 109 Penicillium isolates from various habitats in India. The obtained strains were evaluated by morphological and microscopic examination for genus confirmation. The results were also authenticated with the help of two molecular markers, the ITS and BenA genes. The metabolic taxonomic marker was profiled by liquid chromatography–high resolution mass spectrometry (LC-HRMS). A high-performance liquid chromatographic (HPLC) method was developed for the simultaneous detection of PenV, 6-APA, and POA, which are part of the fermentation system. All isolates were assessed for quantitative PenV production in the submerged fermentation process, quantified by HPLC.
2. Materials and Methods
2.1. Chemicals and Reagents
All the media, medium ingredients, ethyl acetate, amyl acetate, acetonitrile, methanol, and dichloromethane were purchased from HiMedia (Mumbai, India). PenV, POA, 6-APA, and phosphoric acid (H3PO4) were purchased from Sigma Aldrich (Bangalore, India), and formic acid was purchased from Tokyo Chemical Industry (TCI) Chemicals (India).
2.2. Isolation and Morphological Characterization of Fungi
Various food grains, poultry feed, soil, and environmental samples were collected from different sites of Maharashtra, Gujarat, Andhra Pradesh, and Telangana, India. The obtained samples were processed for isolation of fungi using dilution and blotter method and incubated at 25 ± 2 °C for 5 days []. Pure colonies were preserved on the Potato Dextrose Agar (PDA) slants at 4 °C for further use. The isolated colonies were evaluated for species identification using traditional characterization of the colony texture on specific media such as Czapek Yeast Autolysate (CYA), Malt Extract Agar (MEA), Yeast Extract Supplemented (YES), and Creatine Sucrose (CREA). In addition, surface, reverse colony, and microscopic observations including phialides, spore, and conidial arrangement were performed [].
2.3. Molecular Identification of Fungi
A precise identification of fungal species was conducted using dual molecular markers, i.e., ITS region [] and BenA protein-coding gene []. Isolated pure fungal species were grown in CYA broth for five days, and grown mycelia were harvested and lyophilized using cold liquid nitrogen. About 100 mg of the powdered mycelium was used for genomic DNA (gDNA) isolation using DNeasy Plant Mini Kit (QIAGEN, Delhi, India, Pvt. Ltd.) according to manufacturer’s instructions. The purity and concentration of DNA was determined using Nanodrop ND 1000 UV–Vis spectrophotometer (Thermo Scientific, Waltham, MA, USA).
2.3.1. ITS Region Amplification
A Polymerase chain reaction (PCR) was performed in a Thermocycler (Eppendorf, Hamburg, Germany) with gDNA (1 µL), GoTaq Ready-mix (5 µL) (Promega, Mumbai, India), forward and reverse primers (0.25 µL) and total volume was made 10 µL with nuclease-free water. The PCR condition was programmed for 35 cycles as follows: initial denaturation at 94 °C (3 min), denaturation at 94 °C (30 s), annealing at 40 °C (1 min), elongation at 72 °C (1 min) and final elongation at 72 °C. After successful PCR, the amplified product was resolved onto agarose gel electrophoresis (1%) for gene amplification.
2.3.2. BenA Gene Amplification
For BenA gene amplification, a PCR reaction was set up as explained above. The PCR conditions included initial denaturation at 95 °C (5 min), denaturation at 95 °C (1 min), annealing at 55 °C (55 s), elongation at 72 °C (1 min), and final elongation at 72 °C (10 min). PCR was run for 35 cycles. After successful PCR, the amplified product was resolved onto agarose gel electrophoresis (1%) for gene amplification.
2.4. ITS and BenA Gene Sequence Analysis
The positive amplicon of both markers was purified using DNA purification kit (Macherey-Nagel, GmbH, Duren, Germany) according to the manufacturer’s instructions. The amplified PCR product was sent for sequencing to Eurofins Genomics India Pvt. Ltd. (Bangalore, India). Obtained sequences were searched in the National Centre for Biotechnology Information (NCBI) database for the highest sequence similarity and total scores using a basic local alignment tool (BLAST), and strain names were noted for further reference. The evolutionary relationship was analyzed using the Neighbor-joining tree (NJ) method on the maximum composite likelihood model by MEGA 7 software, version 7.1. The bootstrap tree constructed from 1000 replicates and percentage taxa coverage are shown next to the branch.
2.5. Metabolic Profiling Using LC-HRMS
Secondary metabolites are a very efficient tool in the species-level identification in the fungal taxonomy. In this investigation, metabolic profiling was performed using LC-HRMS to differentiate P. chrysogenum and P. rubens []. With minor modification, isolated Penicillium species were grown onto CYA plates for 7 days at 25 °C. At the end of the incubation period, the agar plugs (~6 mm) were taken from the middle of the colony and transferred to the 10 mL screw-cap glass bottle and extracted twice with ethyl acetate, methanol (MeOH), dichloromethane (3:2:1), and formic acid (1%). The organic fraction was concentrated and eluted into MeOH. The final elute was subjected to the further purification step using Solid Phase Extraction (SPE) cartridge Oasis HLB (Waters, Milford, MA, USA). Briefly, the cartridge was equilibrated using 1 mL MeOH:water (50:50) before the purification procedure. Next, the cartridge was washed with 1 mL of MeOH:W=water (5:95), applied to the cartridge and kept stable until the cartridge became completely dried. Finally, the samples were eluted into 1 mL of MeOH and characterized using LC-HRMS []. Briefly, a gradient method consisting of acetonitrile (ACN) with 0.1% formic acid (C) and water with 0.1% formic acid (D). The gradient was first at 2% ©, and 98% (D) for 0–30 s. Next, from 30 s to 10 min (C), it changed from 2% to 45% and (D) from 98% to 55%. From 10 to 13 min (C), it changed from 45% to 98% and (D) from 55% to 2%, which was then changed to 2% (C) and 98% (D) in 30 s and held at the same concentration until the next sample injection. The sample (2 µL) was injected and scanned between 100 and 2000 Da for 15 min. Data acquisition and processing were conducted by X CaliburTM software, version 4.0 (Thermo Scientific, Waltham, MA, USA).
2.6. Biosynthesis of PenV Using Submerged Fermentation
Penicillium chrysogenum/P. rubens are well known for β-lactam antibiotic (PenV/G) production. These isolated species were evaluated for PenV production in the submerged fermentation process. Briefly, 7-day-old P. chrysogenum/P. rubens spore suspension (1 × 108/mL) was prepared using a Neubauer chamber, inoculated into 10 mL of seed medium containing (g/L); KCl—10, Glucose—20, Yeast nitrogen base—6.6, Citric acid—1.5, K2HPO4—6, Yeast extract—2, and incubated at 25 °C under 180 rpm in a shaker incubator (Hi-Point, Kaohsiung, Taiwan) for 24 h. Following incubation, the prepared seed inocula were transferred into 40 mL of newly defined penicillin-producing medium containing (g/L); Glucose—1, Lactose—20, Yeast extract—10, Corn steep liquor—5, Beef extract—0.075, Peptone—0.125, (NH4)2SO4—4, KH2PO4—3, ZnSO4·7H2O—0.01, MgSO4·7H2O—2.3, POA—1, and incubated at 25 °C under 180 rpm for 10 days. After incubation, cultures were harvested and extracted for PenV production.
2.7. Optimization of Fermentation Parameters for PenV Production
The effect of various fermentation parameters including POA concentration (0.05 to 0.10) inoculum size (1 × 106, 1 × 107 and 1 × 108, and 1 × 109 spores/mL), temperature (20, 25, 30, 35, and 40 °C), initial pH of the medium (2–11) and incubation period (10 days) on the growth of P. chrysogenum BIONCL P45 and PenV production were examined. The culture was grown in a 100 mL working volume in a 500 mL Erlenmeyer flask and incubated as described earlier for improved PenV production. After every 24 h of incubation, 10 mL of the sample was withdrawn and analyzed for PenV production by the HPLC method (described in Section 2.10). All the experiments were carried out in triplicate.
2.8. Downstream Processing (DSP) of PenV
At the end of the incubation period, the fermented broth was harvested by filtering the fungal biomass using filter paper, and the obtained cell-free supernatant (CFS) was used for the DSP of PenV []. With minor modifications, the CFS was chilled to 4 °C for 30 min, and pH was adjusted to 2.5 with H2SO4. Subsequently, an equal volume of chilled n-butyl acetate was added and extracted to the acidified broth with horizontal shaking for 5 min. Further, the organic fraction was separated, and an equal volume of cold 10 mM phosphate buffer (pH 7.5) was added. Finally, the aqueous fraction was collected in a clean tube and 1 mL of 0.02% calcium carbonate slurry was added to extract the PenV calcium salt and used for quantitative determination by HPLC. Furthermore, the recovery studies were also conducted by artificially spiking 1% standard PenV in an aqueous sample (Milli Q) and a newly defined penicillin-producing medium for 7 days. At the end of the incubation period, DSP was performed with an equal volume of n-butyl acetate (n 3), as discussed above.
2.9. Antibiotic Sensitivity Assay for PenV Production
A routine antibiotic sensitivity test was performed to check the production of PenV from the fermented broth of test strains. Antimicrobial sensitivity assay was performed against the pre-grown culture of Staphylococcus aureus NCIM-2079 on Muller–Hinton Agar (MHA) plates. A well of 6 mm in diameter was made using a sterile borer, and 50 µL of filtered and extracted broth was added to each well. Positive control was maintained with varying concentrations from 1 µg/mL to 50 µg/mL of standard PenV. Thus, prepared plates were incubated at 37 °C for 18–24 h in an incubator (Genaxy Scientific, New Delhi, India). Following incubation, the zone of inhibition was measured by the Hi antibiotics zone scale (HiMedia, Mumbai, India), and the relative PenV concentration was calculated by comparing it with standard PenV.
2.10. Development of HPLC Method for Detection of PenV, POA, and 6-APA
In this study, the HPLC method for simultaneous detection of 6-APA, PenV, and POA molecules was developed using C18 analytical column X-Bridge, 4.6 × 250 mm in size with 5 µm particle size, 1525 binary pump, 2489 UV–Visible detector, and 2707 autosampler system (Waters, USA). The mobile phase consisting of MeOH: water, ACN: water, and MeOH: ACN: water with varying concentrations and pH were tested for better separation of these molecules. The chromatography analysis was processed by injecting 20 µL of the test sample with a flow rate of 1 mL/min and detected at 210 nm. The separation and quantification of the test sample were compared with the standard graph prepared with standard molecules, 6-APA, PenV, and POA. The limit of detection (LOD), the limit of quantification (LOQ), and the precession of the method were measured by preparing calibration curves of commercial standards.
3. Results
3.1. Isolation and Morphological Identification of Fungal Species
In this study, we aim to landscape an indigenous P. chrysogenum/rubens strain portfolio for PenV production. We have collected various samples for the isolation of Penicillium species and authenticated them on Penicillium specific media. Penicillium species have been identified using traditional approaches such as aerial, reverse colony color and morphology, conidium, colonial ornamentation, pigment formation, and growth rate on CYA medium (Table S1). We have isolated various species belonging to the genera Penicillium, Aspergillus, Scopulariopsis, and Talaromyces based on colonies similar to Penicillium morphology as selection criteria. As a result, we obtained 109 isolates belonging to the P. chrysogenum, P. rubens, P. citrinum, P. brocae, P. oxalicum, P. dipodomyicola, A. sydowii, A. fumigatus and T. tratensis species. Penicillium species were determined to be the dominant genus among them (Table 1).

Table 1.
Molecular characterization and screening of Penicillium chrysogenum/rubens strains and PenV production.
The phenotypic differentiation of closely related Penicillium species, mostly P. chrysogenum and P. rubens, is firmly linked, which is difficult to distinguish (Figure 1). The colony colors of most isolates were creamy white, bluish green to light green aerially, and yellow, pale yellow to brownish yellow in reverse. Despite this, interestingly, the differential growth pattern with floccose white growth with dark brown reverse coloration was sown by P. brocae BIONCL P81 strain which is similar to A. sydowii BIONCL P95 isolated from soil. The different geographical locations and habitats may cause variations in the growth pattern.


Figure 1.
Morphological observation of isolated species. A—P. rubens, B—P. chrysogenum, C—P. citrinum, D—P. brocae, E—P. oxalicum, F—P. dipodomyicola, G—T. tratensis, H—A. sydowii, I—A. fumigatus, J—S. brevicaulis; 1—aerial, 2—revers, 3 and 4—microscopic observation (Magnification 400×).
3.2. Molecular Identification by ITS Regions
The ITS and BenA gene markers have been used to identify fungal species. Following successful gene amplification, all the strains were chosen for the BLASTn analysis at NCBI. The nucleotide sequences displayed with high query coverage and sequence similarity (to 98%) were assigned the same species name. A total of 109 isolates were analyzed with ITS marker, out of which 40 isolates showed the closest similarity with P. chrysogenum, and 34 isolates were similar to P. rubens. The rest of the isolates belong to P. citrinum, P. brocae, P. oxalicum, P. dipodomyicola, A. sydowii, A. fumigatus and T. tratensis (Figure 2).

Figure 2.
Phylogenetic analysis of the isolates based on the ITS sequencing.
3.3. Molecular Identification by BenA Gene
All the isolates were analyzed with the BenA gene for precise identification of closely related species complexes; 39 isolates showed the closest similarity with P. chrysogenum and 41 with P. rubens. Penicillium oxalicum and P. dipodomyicola strains from ITS identification showed similarity with P. rubens when analyzed with the BenA gene. Other isolates from Aspergillus, Scopulariopsis, and Tratensis genera fall under the same genus with BenA gene identification. ITS failed to differentiate between the closely related strains of the Penicillium genus to some extent. Furthermore, a phylogenetic tree was constructed for all isolates analyzed and revealed that they clustered in groups with a close resemblance. Concerning P. chrysogenum and P. rubens differentiation, the BenA marker gene showed a distinct grouping formation compared to the ITS marker (Figure 3). The BenA gene showed a separate grouping from the ITS region within the Penicillium genus, mainly P. chrysogenum and P. rubens.

Figure 3.
Phylogenetic analysis of the isolates based on the BenA marker sequencing.
3.4. Metabolic Profiling by LC–HRMS
Metabolic profiling is a recognizable proof in fungal taxonomy for the precise segregation of species. In this investigation, one representative strain of P. chrysogenum and P. rubens was profiled by LC-HRMS. Roquefortine C, chrysogine, sorbicillin, meleagrin, andrastin A, xanthocillin X, secalonic acid D, lumpedin, and penicillin are produced by the P. chrysogenum (Figure 4). Moreover, P. rubens can produce all metabolites except secalonic acid, meleagrin, and roquefortine C. The results suggest that P. chrysogenum strain can be distinguished from P. rubens using metabolite production. Nevertheless, both strains showed diversity in PenV production and other metabolites.





Figure 4.
Extrolite analysis of P. chrysogenum by LC-HRMS (Q-exactive-orbitrap Mass Spectrometer) with a positive ionization mode. A—roquefortine C, B—chrysogine, C—sorbicillin, D—meleagrin, E—andrastin A, F—xanthocillin X, G—secalonic acid, H—lumpidin, I—penicillin.
3.5. PenV Production
Isolated and authenticated Penicillium strains were screened for PenV production in a newly defined penicillin-production medium. After screening of 80 P. chrysogenum/rubens strains for PenV production, 28 were determined to be capable of producing 10–100 mg/L of PenV in submerged fermentation, quantified by HPLC (Table 1). Among all screened strains, Penicillium rubens strain BIONCL P45 was determined to be the highest PenV producer. This strain was chosen for further studies for enhanced antibiotics production by optimizing various fermentation and other important parameters.
3.6. Optimization Fermentation Parameters
Various fermentation parameters including POA concentration, incubation period, inoculum size, pH, and temperature were monitored for the improved PenV production using P. rubens BIONCL P45 strain. Here, POA was used as precursor for biosynthesis of PenV. Moreover, POA has also been used in certain herbicide and antifungal drugs. Hence, the effect of POA concentration on vegetative growth and PenV production by P. rubens was studied. Interestingly, no significant impact was observed on vegetative growth (Figure 5). However, biosynthesis of PenV was severely affected. A maximum PenV production was observed when inoculated with 0.01% POA, and biosynthesis of PenV was reduced with increasing and decreasing concentrations (Figure 6A). In addition, at higher concentration, traces of POA remain unutilized and affect DSP and PenV quantification. Results suggest that biosynthesis of PenV began at 72 h of incubation, and on the 5th day, there was a sharp rise in its production. On the 8th day of an extended incubation period, 101 mg/L of product was produced. However, further incubation did not result in an increase in PenV titer (Figure 6B).

Figure 5.
Effect of POA concentration on growth and biomass of P. rubens BIONCL P45. C—Control, 0.1 to 1.0 concentration of POA (%).

Figure 6.
Optimization of fermentation parameters for PenV production by P. rubens BIONCL P45. (A)—POA concentration optimization, (B)—Effect of incubation time on PenV production, (C)—Effect of inoculum size on PenV production, (D)—Effect of temperature on PenV production, (E)—Effect of initial pH on PenV production.
Furthermore, the optimal production of PenV was achieved with 1 × 108 spore inoculum. With low number of spores in inoculum, mycelium formed a ball-like pellet structure in the production medium. As inoculum size increases, the growth of mycelia changes from pellets to pulpy with decrease in PenV production, and this might occur because of limitation in nutrients and oxygen supply (Figure 6C). Incubation temperature evaluated from 20 to 40 °C, and P. rubens exhibited high PenV production (101 mg/L) at 25 °C, and bellow and above 25 °C it exhibited a sharp reduction in its biosynthesis (Figure 6D). In addition, since initial pH of the medium affects the PenV production, the optimum pH was determined to be 5. Below and above, a decrease in PenV, and at extreme pH values (3 and 9), no cell growth was observed (Figure 6E).
3.7. DSP and Recovery of PenV
DSP was performed to harvest the PenV from the whole fermented broth in pure form. To evaluate the percent of recovery, the spiking study of standard 1% PenV was performed in PenV production medium. As mentioned in the methodology, the extraction was performed three times with butyl acetate, and finally, the eluted PenV in aqueous phase was quantified by HPLC. In the first extraction cycle, about 61% recovery rate was observed. Second cycle of extraction was performed with organic phase remaining in first cycle, and the 8% PenV was extracted. Finally, in the third cycle of extraction, about 3% of recovery was observed. In all three cycles, overall, a 72% recovery rate was observed, and 28% of PenV was lost during the extraction, which might be due to the lower pH and the organic solvent used in the process. Finally, PenV was harvested from the fermented broth and quantified by HPLC.
3.8. Antibiotic Plate Assay
Antibiotic assay is routinely used to confirm the antimicrobial activity of drugs/molecules. The fermented broth was extracted for PenV production, its activity evaluated against S. aureus NCIM-2079. The antimicrobial activity and HPLC results were positively correlated and used to screen the strains for PenV production. The tested strain showed a 10 to 38 mm zone of inhibition (Table S2, Figure S1). The data of test samples produce 10 to 100 mg/L PenV when compared with standard PenV.
3.9. Development of an HPLC Method for the Detection of PenV, POA, and 6-APA
In this investigation, precise HLPC method was developed for simultaneous, quantitative detection of PenV, POA, and 6-APA. Results reported that ACN:water (50:50), pH 3.0 was the most suitable for the distinct separation. Retention times for 6-APA, POA, and PenV were recorded at 2.49, 3.72, and 4.39 min, respectively, with good resolution (Figure 7). The calibration curve was plotted by considering the peak area and the relative concentration (Figure S2), and then the regression equation was computed for each of the molecules; the values are listed in Table 2. Correlation coefficients (R2), 0.9988 and 0.9999, were observed for PenV and 6-APA, respectively. However, (R2) 0.9373 was determined for POA.

Figure 7.
Quantitative analysis of PenV and simultaneous detection of 6-APA, POA, and PenV by HPLC method.

Table 2.
Validation parameters of the developed HPLC method for detection of Pen V, 6-APA, and POA.
Furthermore, to check the limit of detection (LOD) and limit of quantitation (LOQ), lower concentrations from 1 to 10 µg/mL were tested, and it was determined that the developed method can detect the molecules from 5 to 10 µg/mL and can quantify them from 10 µg/mL. The developed method distinctly separates the PenV, 6-APA, and POA from the mixture quickly and precisely. All the samples were processed in a triplicate to check the reproductivity of the method.
4. Discussion
Penicillium rubens (formerly named P. notatum) was the first penicillin-producing microorganism isolated by Sir Alexander Flaming, and the bioactive molecule penicillin was characterized by Howard Walter Florey and Ernst Boris Chain []. Subsequently, findings suggest various species of Penicillium, Aspergillus, and Fusarium which have been characterized for their ability to produce penicillins and their industrially important drugs/molecules []. In this investigation, we isolated various strains of P. chrysogenum/rubens from diverse habitats, such as India [,,]. Isolated species were examined on Penicillium-specific media for morphological characterization and distinguishing Penicillium species [,,]. Traditionally, colony color, texture, size, spore shape, and exudate formation are the key features used for morphological differentiation of Penicillium species and helpful in species differentiation to date [,]. Unfortunately, in most cases, morphological and microscopic observations help identifying genus and certain species, but not closely related species, which can be overcome by using molecular markers. Since differentiation of all penicillium species is difficult by morphological observations, multilocous sequence analysis (MLSA) such as ITS, BenA, CaM, NL, and LR are really helpful to identify complex species []. We have isolated and prepared an indigenous strain portfolio for the P. chrysogenum/rubens for PenV production. The ITS is the universally accepted official DNA barcode for the fungal taxonomy []. Unfortunately, all closely related species of verticillate Penicillium and ascomycetes have not differentiated in the ITS barcode. Due to their taxonomic difficulties, protein-coding genes are often required for species-level differentiation, which has been validated by BenA marker [,,]. Recent classification suggests two clades representing P. chrysogenum and P. rubens, and concludes P. rubens is the original flaming penicillin-producing strain []. In our study, the ITS sequence analysis of 109 strains revealed that about 40 isolates were closely related to P. chrysogenum, and 34 strains mapped to P. rubens. Furthermore, these strains were analyzed with the BenA marker to verify the species identification; unexpectedly, P. chrysogenum, P. oxalicum, and P. dipodomyicola strains showed similarity with P. rubens mapped in common clade with P. chrysogenum and P. rubens []. Hence, we have performed several assays and metabolic profiling of reported molecules for distinguishing closely related species []. Penicillium strains are known for producing important molecules; of note, P. chrysogenum strains produce sorbicillin, meleagrin, xanthocillin X, roquefortine C, andrastin A, secalonic acid, penicillin, and chrysogine []. On the other hand, no such reports are available for the biosynthesis of secalonic acid, meleagrin, and roquefortine C by P. rubens. P. rubens clade is best known for penicillin, roquefortine C, chrysogine, meleagrin, sorbicillin, and xanthocillin X []. Moreover, P. chrysogenum clade produces secalonic acids D, F, and lumpidin-like compounds along with metabolites produced by P. rubens strains []. Penicillium strains are known for producing essential molecules, including enzymes, organic acids, terpenoids, and polyketides used in various industries (Table 3) [,,,,,,,,,,,,,,,,,,,,,,,,,,,,,,,,].

Table 3.
Metabolites produced by different fungal species and their applications.
The pivotal aim of the study is the development of candidate P. chrysogenum/rubens strains for PenV production. The prepared library of 80 strains of both or either P. chrysogenum/rubens were evaluated for production of PenV. The precise method is important for quantification of the produced molecules in fermentation. Hence, HPLC method is a critical process in identifying different pharmaceutical products []. The separation of the structurally related compounds is dependent upon the selection of mobile phase composition, pH, column type, etc. We have developed a precise, sensitive, and reliable liquid chromatographic method for simultaneous quantitative detection of PenV, 6-APA, and POA. Among the studied mobile phases, ACN:water (50:50) and pH 3 with H3PO4 showed good separation of studied molecules. The combination of ACN and water (60:40) with pH 4 by H3PO4 was successfully used for the separation of the β-lactam antibiotic and 6-APA []. Our developed method showed the distinct peaks of individual molecules in mixture, as well as reproducibility.
In order to enhance the production of PenV, optimization of nutritional parameters is very important []. In our study, the POA concentration from 0.1 to 1% was tested for effect on growth, and 0.005 to 0.1% concentration was tested for PenV production. The precursor concentration between 0.1 and 1% did not negatively affect growth. Furthermore, 0.01% POA resulted in higher PenV biosynthesis and further increases in POA concentration there is reduction in PenV titer. Industrial PenV producing strains utilize more than 2.5% of POA []. However, all the strains are unable to utilize the higher precursor concentration and may affect growth and PenV production. Conventional penicillin production in a defined medium containing corn steep liquor, glucose, lactose, minerals, oil, and specific precursors enhances the production of the P. chrysogenum Q176 strain [,,]. Inoculum size, temperature, incubation period, and initial pH majorly affects the penicillin titer []. The optimum inoculum size for higher penicillin production and mycelial growth is 107 spores/dm3, but this is not always the same for all the strains []. Kumar and co-workers [] studied the optimum penicillin production at 26 °C; the optimum production temperature varies from 23 to 28 °C, but good mycelium growth was discovered at 30 °C [,]. Our results are positively correlated with those reported by Kumar et al. [] at 25 °C, and the active time of PenV production is 6–8 days []. PenV production is very sensitive to the initial pH of the inoculum media, and it was observed that a pH less than 4 or more than 7 was not suitable for growth and product formation []. Finally, the studied P. rubens BIONCL P45 strain produced the highest PenV at pH 5 on the 8th day with 1 × 108 spores and 0.01% POA concentration. Furthermore, more studies are needed, including classical and genetic engineering approaches, for the development of industrial PenV-producing P. rubens strains to ensure bulk API production.
5. Conclusions
In the present study, 80 P. chrysogenum/rubens strains were collected from diverse habitats in India. Dual molecular markers, ITS, and BenA barcodes were used for species differentiation. An array of new techniques and molecular and biochemical methods must be improved in the fungal taxonomy of industrial importance. An inherent variability in species of Penicillium constitutes a serious problem for taxonomists due to new physiological approaches. Furthermore, 35% of isolated strains were capable of producing PenV at very low levels. Further, repetitive DSP could able to achieve 72% of PenV. The chromatographic method precisely detected the product, precursors, and by-products. A promising strain of P. rubens BIONCL P45 was explored for PenV production, and various fermentation parameters were optimized for enhanced PenV production at the lab scale. It can be explored for the industrial-scale production of PenV to substitute imports. More detailed studies are needed to understand the biosynthetic pathway genes, compartmentalization, nutrient uptakes, and transporter proteins for commercial PenV production.
Supplementary Materials
The following supporting information can be downloaded at: https://www.mdpi.com/article/10.3390/microorganisms11051132/s1, Figure S1: Antibiotic plate assay with S. aureus NCIM-2079 culture. Group 1—Std. PenV with varying concentration (1 µg/mL to 50 µg/mL), Group 2—Extracted PenV from culture broth, Group 3—Cell-free supernatant (CSF); Figure S2: Calibration curve of A—PenV, B—6-APA, C—POA. Table S1: Isolation, identification, morphological and molecular identification of fungal spp. isolated from food and environmental samples; Table S2: Antimicrobial test zone of inhibition.
Author Contributions
Author A.M.S. carried out the all-experimentation part, sample collection, data analysis, bioinformatic study and manuscript writing. V.D.N. helped in molecular data analysis and manuscript drafting. K.R.V. helped in experiment designing, data analysis, manuscript writing and editing. All authors have read and agreed to the published version of the manuscript.
Funding
This work was financially supported by Council of Scientific and Industrial Research-Focused Basic Research (CSIR-FBR) scheme, New Delhi, India (Project No-MLP101126).
Institutional Review Board Statement
Not applicable.
Informed Consent Statement
Not applicable.
Data Availability Statement
Please contact author for data request.
Acknowledgments
The authors thank the CSIR-National Chemical Laboratory, Pune, India for the necessary facilities.
Conflicts of Interest
Authors declare no conflict of interest.
References
- Wu, B.; Hussain, M.; Zhang, W.; Stadler, M.; Liu, X.; Xiang, M. Current insights into fungal species diversity and perspective on naming the environmental DNA sequences of fungi. Mycology 2019, 10, 127–140. [Google Scholar] [CrossRef] [PubMed]
- Navale, V.; Vamkudoth, K.R.; Ajmera, S.; Dhuri, V. Aspergillus derived mycotoxins in food and the environment: Prevalence, detection, and toxicity. Toxicol. Rep. 2021, 8, 1008–1030. [Google Scholar] [CrossRef] [PubMed]
- Wang, Y.P.; Chen, Y.C.; Chang, W.; Lin, C.L. Mutant Strain of Penicillium citrinum and Use Thereof for Preparation of Compactin. U.S. Patent 6323021, 27 November 2001. [Google Scholar]
- Houbraken, J.; Frisvad, J.C.; Samson, R.A. Fleming’s penicillin producing strain is not Penicillium chrysogenum but P. rubens. IMA Fungus 2011, 2, 87–95. [Google Scholar] [CrossRef] [PubMed]
- Refai, M.; El-Yazid, H.A.; Tawakkol, W. Monograph on the Genus Penicillium: A Guide for Historical, Classification, and Identification of Penicillin, their Industrial Applications and Detrimental Effects; Cairo University: Giza, Egypt, 2015. [Google Scholar]
- Shaaban, M.; Sohsah, G.E.; Magdy El-Metwally, M.; Elfedawy, M.G.; Abdel-Mogib, M. Bioactive compounds produced by strain of Penicillium sp. Int. J. Eng. Appl. 2016, 5, 7560. [Google Scholar] [CrossRef]
- Leitão, A.L.; Enguita, F.J. Gibberellins in Penicillium strains: Challenges for endophyte-plant host interactions under salinity stress. Microbiol. Res. 2016, 183, 8–18. [Google Scholar] [CrossRef]
- Boruta, T.; Przerywacz, P.; Ryngajllo, M.; Bizukojc, M. Bioprocess-related, morphological and bioinformatic perspectives on the biosynthesis of secondary metabolites produced by Penicillium solitum. Process Biochem. 2018, 68, 12–21. [Google Scholar] [CrossRef]
- Bilal, S.; Shahzad, R.; Khan, A.L.; Al-Harrasi, A.; Kim, C.K.; Lee, I.J. Phytohormones enabled endophytic Penicillium funiculosum LHL06 protects Glycine max L. from synergistic toxicity of heavy metals by hormonal and stress-responsive proteins modulation. J. Hazard. Mater. 2019, 379, 120824. [Google Scholar] [CrossRef]
- Kozlovsky, A.G.; Kochkina, G.A.; Zhelifonova, V.P.; Antipova, T.V.; Ivanushkina, N.E.; Ozerskaya, S.M. Secondary metabolites of the genus Penicillium from undisturbed and anthropogenically altered Antarctic habitats. Folia. Microbiol. 2020, 65, 95–102. [Google Scholar] [CrossRef]
- Visagie, C.M.; Houbraken, J.; Frisvad, J.C.; Hong, S.B.; Klaassen, C.H.; Perrone, G.; Seifert, K.A.; Varga, J.; Yaguchi, T.; Samson, R.A. Identification and nomenclature of the genus Penicillium. Stud. Mycol. 2014, 78, 343–371. [Google Scholar] [CrossRef]
- Frisvad, J.C.; Samson, R.A. Polyphasic taxonomy of Penicillium subgenus Penicillium: A guide to identification of food and air-borne terverticillate Penicillia and their mycotoxins. Stud. Mycol. 2004, 49, 1–173. [Google Scholar]
- Sawant, A.M.; Vankudoth, R.; Navale, V.; Kumabat, R.; Kumari, P.; Shantakumari, B.; Vamkudoth, R.V. Morphological and molecular characterization of Penicillium rubens sp. nov isolated from poultry feed. Indian Phytopathol. 2019, 72, 461–478. [Google Scholar] [CrossRef]
- White, T.J.; Bruns, T.; Lee, S.; Taylor, J. Amplification of direct sequencing of fungal ribosomal RNA genes for phylogenetics. In PCR Protocols: A Guide to Method and Applications; Innis, D., Gelfand, H., Sninsky, J.J., Eds.; Academic Press Inc.: New York, NY, USA, 1990. [Google Scholar]
- Schoch, C.L.; Seifert, K.A.; Huhndorf, S.; Robert, V.; Spouge, J.L.; Levesque, C.A.; Chen, W. Nuclear ribosomal internal transcribed spacer (ITS) region as a universal DNA barcode marker for Fungi. Proc. Natl. Acad. Sci. USA 2012, 109, 6241–6246. [Google Scholar] [CrossRef] [PubMed]
- Morán-Díaz, J.R.; Jiménez-Vázquez, H.A.; Gómez-Pliego, R.; Arellano-Mendoza, M.G.; Quintana-Zavala, D.; Guevara-Salazar, J.A. Correlation study of antibacterial activity and spectrum of Penicillins through a structure-activity relationship analysis. Med. Chem. Res. 2019, 28, 1529–1546. [Google Scholar] [CrossRef]
- Chandel, A.K.; Rao, L.V.; Narasu, M.L.; Singh, O.V. The realm of penicillin acylase in beta-lactam antibiotics. Enzyme Microb. Technol. 2008, 42, 199–207. [Google Scholar] [CrossRef]
- Nandi, A.; Pan, S.; Potumarthi, R.; Danquah, M.K.; Sarethy, I.P. A proposal for six sigma integration for large-scale production of penicillin G and subsequent conversion to 6-APA. J. Anal. Methods Chem. 2014, 2014, 413616. [Google Scholar] [CrossRef]
- Sawant, A.M.; Sunder, A.V.; Vamkudoth, K.R.; Ramasamy, S.; Pundle, A. Process development for 6-Aminopenicillanic acid production using lentikats-encapsulated Escherichia coli Cells expressing penicillin V acylase. ACS Omega 2020, 5, 28972–28976. [Google Scholar] [CrossRef]
- Ventola, C.L. The antibiotic resistance crisis: Part 1: Causes and threats. Pharm. Ther. 2015, 40, 277–283. [Google Scholar]
- Glass, N.L.; Donaldson, G.C. Development of primer sets designed for use with the PCR to amplify conserved genes from filamentous ascomycetes. Appl. Environ. Microbiol. 1995, 61, 1323–1330. [Google Scholar] [CrossRef]
- Smedsgaard, J. Micro-scale extraction procedure for standardized screening of fungal metabolite production in cultures. J. Chromatogr. A 1997, 760, 264–270. [Google Scholar] [CrossRef]
- Yakhkind, M.I.; Tarantseva, K.R.; Marynova, M.A.; Storozhenko, P.A.; Rasulov, M.M. Recovery of biosynthetic penicillins. In Advances in Medicine and Biology; Nova Science Publishers: Hauppauge, NY, USA, 2014; Volume 79. [Google Scholar]
- Raper, K.B.; Thom, C. A Manual of the Penicillia; Williams & Wilkins: Baltimore, ML, USA, 1949; pp. 368–370. [Google Scholar]
- Dulaney, E.L. Penicillin production by the Aspergillus nidulans group. Mycologia 1947, 39, 582–586. [Google Scholar] [CrossRef]
- Rao, V.K.; Shilpa, P.; Girisham, S.; Reddy, S.M. Incidence of mycotoxigenic penicillia in feeds of Andhra Pradesh, India. Int. J. Biotechnol. Mol. Biol. Res. 2011, 2, 46–50. [Google Scholar]
- Rao, V.K.; Girisham, S.; Reddy, S.M. Prevalence of toxigenic Penicillium species associated with poultry house in Telangana, India. Arch. Environ. Occup. Health 2016, 71, 353–361. [Google Scholar]
- Dayalan, S.A.; Darwin, P.; Prakash, S. Comparative study on production, purification of penicillin by Penicillium chrysogenum isolated from soil and citrus samples. Asian Pac. J. Trop. Biomed. 2011, 1, 15–19. [Google Scholar] [CrossRef] [PubMed]
- Yin, G.; Zhang, Y.; Pennerman, K.K.; Wu, G.; Hua, S.S.T.; Yu, J.; Jurick, W.M.; Guo, A.; Bennett, J.W. Characterization of blue mold penicillium species isolated from stored fruits using multiple highly conserved loci. J. Fungi 2017, 3, 12. [Google Scholar] [CrossRef] [PubMed]
- Barbosa, R.N.; Bezerra, J.D.P.; Souza-Motta, C.M.; Frisvad, J.C.; Samson, R.A.; Oliveira, N.T.; Houbraken, J. New Penicillium and Talaromyces species from honey, pollen and nests of stingless bees. Antonie Van Leeuwenhoek 2018, 111, 1883–1912. [Google Scholar] [CrossRef] [PubMed]
- Houbraken, J.; Samson, R.A. Phylogeny of Penicillium and the segregation of Trichocomaceae into three families. Stud. Mycol. 2011, 70, 1–51. [Google Scholar] [CrossRef]
- Peterson, S.W. Phylogenetic analysis of Penicillium species based on ITS and LSU-rDNA nucleotide sequences. In Integration of Modern Taxonomic Methods for Penicillium and Aspergillus Classification; Samson, R.A., Pitt, J.I., Eds.; Harwood Academic Publishers: Amsterdam, The Netherlands, 2000; pp. 163–178. [Google Scholar]
- Abastabar, M.; Mirhendi, H.; Hedayati, M.T.; Shokohi, T.; Rezaei-Matehkolaei, A.; Mohammadi, R.; Badali, H.; Moazeni, M.; Haghani, I.; Ghojoghi, A.; et al. Genetic and morphological diversity of the genus Penicillium from Mazandaran and Tehran Provinces, Iran. Jundishapur J. Microbiol. 2016, 9, e28280. [Google Scholar] [CrossRef] [PubMed]
- Villarino, M.; De Cal, A.; Melgarejo, P.; Larena, I.; Espeso, E.A. The development of genetic and molecular markers to register and commercialize Penicillium rubens (formerly Penicillium oxalicum) strain 212 as a biocontrol agent. Microb. Biotechnol. 2016, 9, 89–99. [Google Scholar] [CrossRef]
- Cruickshank, R.H.; Pitt, J.I. The zymogram technique: Isoenzyme patterns as an aid in Penicillium classification. Microbiol. Sci. 1987, 4, 14–17. [Google Scholar]
- Houbraken, J.; Frisvad, J.C.; Seifert, K.A.; Overy, D.P.; Tuthill, D.M.; Valdez, J.G.; Samson, R.A. New penicillin-producing Penicillium species and an overview of section Chrysogena. Persoonia 2012, 29, 78–100. [Google Scholar] [CrossRef]
- de la Campa, R.; Seifert, K.; Miller, J.D. Toxins from strains of Penicillium chrysogenum isolated from buildings and other sources. Mycopathologia 2007, 163, 161–168. [Google Scholar] [CrossRef] [PubMed]
- Bugni, T.S.; Bernan, V.S.; Greenstein, M.; Janso, J.E.; Maiese, W.M.; Mayne, C.L.; Ireland, C.M. Brocaenols A-C: Novel polyketides from a marine derived Penicillium brocae. J. Org. Chem. 2003, 68, 2014–2017. [Google Scholar] [CrossRef] [PubMed]
- Peterson, S.W.; Pérez, J.; Vega, F.E.; Infante, F. Penicillium brocae, a new species associated with the coffee berry borer in Chiapas, Mexico. Mycologia 2003, 95, 141–147. [Google Scholar] [CrossRef]
- Wang, L.; Zhang, X.; Zhang, K.; Zhang, X.; Zhu, T.; Che, Q.; Zhang, G.; Li, D. Overexpression of global regulator Pbrlaea leads to the discovery of new polyketide in fungus Penicillium brocae HDN-12-143. Front. Chem. 2020, 8, 270. [Google Scholar] [CrossRef] [PubMed]
- Meng, L.H.; Li, X.M.; Lv, C.T.; Huang, C.G.; Wang, B.G. Brocazines A-F, cytotoxic bisthiodiketopiperazine derivatives from Penicillium brocae ma-231, an endophytic fungus derived from the marine mangrove plant Avicennia marina. J. Nat. Prod. 2014, 77, 1921–1927. [Google Scholar] [CrossRef] [PubMed]
- Meng, L.H.; Zhang, P.; Li, X.M.; Wang, B.G. Penicibrocazines A–E, five new sulfide diketopiperazines from the marine-derived endophytic fungus Penicillium brocae. Mar. Drugs 2015, 13, 276–287. [Google Scholar] [CrossRef]
- Meng, L.H.; Wang, C.Y.; Mándi, A.; Li, X.M.; Hu, X.Y.; Kassack, M.U.; Kurtán, T.; Wang, B.G. Three diketopiperazine alkaloids with spirocyclic skeletons and one bisthiodiketopiperazine derivative from the mangrove-derived endophytic fungus Penicillium brocae MA-231. Org. Lett. 2016, 18, 5304–5307. [Google Scholar] [CrossRef]
- Chu, Y.C.; Chang, C.H.; Liao, H.R.; Cheng, M.J.; Wu, M.D.; Fu, S.L.; Chen, J.J. Rare chromone derivatives from the marine-derived Penicillium citrinum with anticancer and anti-inflammatory activities. Mar. Drugs 2021, 19, 25. [Google Scholar] [CrossRef]
- Chu, Y.C.; Chang, C.H.; Liao, H.R.; Fu, S.L.; Chen, J.J. Anti-cancer and anti-inflammatory activities of three new chromone derivatives from the marine-derived Penicillium citrinum. Mar. Drugs 2021, 19, 408. [Google Scholar] [CrossRef]
- da Costa, S.G.; Pereira, O.L.; Teixeira-Ferreira, A.; Valente, R.H.; de Rezende, S.T.; Guimarães, V.M.; Genta, F.A. Penicillium citrinum UFV1 β-glucosidases: Purification, characterization, and application for biomass saccharification. Biotechnol. Biofuels 2018, 11, 226. [Google Scholar] [CrossRef]
- Salendra, L.; Lin, X.; Chen, W.; Pang, X.; Luo, X.; Long, J.; Liao, S.; Wang, J.; Zhou, X.; Liu, Y.; et al. Cytotoxicity of polyketides and steroids isolated from the sponge-associated fungus Penicillium citrinum SCSIO 41017. Nat. Prod. Res. 2021, 35, 900–908. [Google Scholar] [CrossRef]
- Thissera, B.; Sayed, A.M.; Hassan, M.; Abdelwahab, S.F.; Amaeze, N.; Semler, V.T.; Alenezi, F.N.; Yaseen, M.; Alhadrami, H.A.; Belbahri, L.; et al. Bioguided isolation of cyclopenin analogues as potential SARS-CoV-2 Mpro inhibitors from Penicillium citrinum TDPEF34. Biomolecules 2021, 11, 1366. [Google Scholar] [CrossRef] [PubMed]
- Maketon, M.; Amnuaykanjanasin, A.; Kaysorngup, A. A rapid knockdown effect of Penicillium citrinum for control of the mosquito Culex quinquefasciatus in Thailand. World J. Microbiol. Biotechnol. 2014, 30, 727–736. [Google Scholar] [CrossRef]
- Khan, S.A.; Hamayun, M.; Yoon, H.; Kim, H.Y.; Suh, S.J.; Hwang, S.K.; Kim, J.M.; Lee, I.J.; Choo, Y.S.; Yoon, U.H.; et al. Plant growth promotion and Penicillium citrinum. BMC Microbiol. 2008, 8, 231. [Google Scholar] [CrossRef] [PubMed]
- Jin, X.; Song, J.; Ma, J.; Liu, G.Q. Thermostable β-xylosidase from Aspergillus fumigatus: Purification, characterization and potential application in lignocellulose bioethanol production. Renew. Energy 2020, 155, 1425–1431. [Google Scholar] [CrossRef]
- Liu, D.; Zhang, R.; Yang, X.; Wu, H.; Dabing, X.; Tang, Z.; Shen, Q. Thermostable cellulase production of Aspergillus fumigatus Z5 under solid-state fermentation and its application in degradation of agricultural wastes. Int. Biodeterior. Biodegrad. 2011, 65, 717–725. [Google Scholar] [CrossRef]
- Singh, S.; Mangla, J.; Singh, S. Evaluation of Aspergillus fumigatus NTCC1222 as a source of enzymes for detergent industry. Resour. Environ. Sustain. 2021, 5, 100030. [Google Scholar] [CrossRef]
- Okonji, R.E.; Itakorode, B.O.; Ovumedia, J.O.; Adedeji, O.S. Purification and biochemical characterization of pectinase produced by Aspergillus fumigatus isolated from soil of decomposing plant materials. J. Appl. Biol. Biotechnol. 2019, 7, 1–8. [Google Scholar]
- Suresh, N.; Das, A. Purification and characterization of phosphatases from Aspergillus fumigatus for applications in industrial uses. Rasayan. J. Chem. 2014, 7, 118–128. [Google Scholar]
- Alwakeel, S.S.; Ameen, F.; Al Gwaiz, H.; Sonbol, H.; Alghamdi, S.; Moharram, A.M.; Al-Bedak, O.A. Keratinases produced by Aspergillus stelliformis, Aspergillus sydowii, and Fusarium brachygibbosum isolated from human hair: Yield and activity. J. Fungi 2021, 7, 471. [Google Scholar] [CrossRef]
- Amin, M.; Liang, X.; Ma, X.; Dong, J.D.; Qi, S.H. New pyrone and cyclopentenone derivatives from marine-derived fungus Aspergillus sydowii SCSIO 00305. Nat. Prod. Res. 2021, 35, 318–326. [Google Scholar] [CrossRef] [PubMed]
- Niu, S.; Chen, Z.; Pei, S.; Shao, Z.; Zhang, G.; Hong, B. Acremolin D, a new acremolin alkaloid from the deep-sea sediment derived Aspergillus sydowii fungus. Nat. Prod. Res. 2022, 36, 4936–4942. [Google Scholar] [CrossRef] [PubMed]
- Li, W.T.; Luo, D.; Huang, J.N.; Wang, L.L.; Zhang, F.G.; Xi, T.; Liao, J.M.; Lu, Y.Y. Antibacterial constituents from Antarctic fungus, Aspergillus sydowii SP-1. Nat. Prod. Res. 2018, 32, 662–667. [Google Scholar] [CrossRef] [PubMed]
- Eakjamnong, W.; Keawsalong, N.; Dethoup, T. Novel ready-to-use dry powder formulation of Talaromyces tratensis KUFA0091 to control dirty panicle disease in rice. Biol. Control 2021, 152, 104454. [Google Scholar] [CrossRef]
- Suasa-ard, S.; Eakjamnong, W.; Dethoup, T. A novel biological control agent against postharvest mango disease caused by Lasiodioplodia theobromae. Eur. J. Plant Pathol. 2019, 155, 583–592. [Google Scholar] [CrossRef]
- Al-Hawash, A.B.; Al-Qurnawi, W.S.; Abbood, H.A.; Hillo, N.A.; Ghalib, H.B.; Zhang, X. Pyrene-degrading fungus Ceriporia lacerata RF-7 from contaminated soil in Iraq. Polycycl. Aromat. Compd. 2022, 42, 40–48. [Google Scholar] [CrossRef]
- Yu, Z.; Lang, G.; Kajahn, I.; Schmaljohann, R.; Imhoff, J.F. Scopularides A and B, cyclodepsipeptides from a marine sponge-derived fungus, Scopulariopsis brevicaulis. J. Nat. Prod. 2008, 71, 1052–1054. [Google Scholar] [CrossRef]
- Anbu, P.; Gopinath, S.C.; Hilda, A.; Lakshmipriya, T.; Annadurai, G. Optimization of extracellular keratinase production by poultry farm isolate Scopulariopsis brevicaulis. Bioresour. Technol. 2007, 98, 1298–1303. [Google Scholar] [CrossRef]
- Santi, L.; Beys-da-Silva, W.O.; Berger, M.; Yates, J.R.; Brandelli, A.; Vainstein, M.H. Penicillium oxalicum secretomic analysis identify plant cell wall degrading enzymes important for fruit juice extraction. J. Food Sci. Technol. 2021, 58, 1764–1775. [Google Scholar] [CrossRef]
- Zhang, J.; Liu, S.; Sun, H.; Jiang, Z.; Zhou, Z.; Han, X.; Zhou, Y.; Sun, H.; Zhou, W.; Mao, J. Enzyme production potential of Penicillium oxalicum M1816 and Its application in ferulic acid production. Foods 2021, 10, 2577. [Google Scholar] [CrossRef]
- Kaur, R.; Kaur, J.; Kaur, M.; Kalotra, V.; Chadha, P.; Kaur, A.; Kaur, A. An endophytic Penicillium oxalicum isolated from Citrus limon possesses antioxidant and genoprotective potential. J. Appl. Microbiol. 2020, 128, 1400–1413. [Google Scholar] [CrossRef] [PubMed]
- Wang, J.; Zhao, Y.G.; Maqbool, F. Capability of Penicillium oxalicum y2 to release phosphate from different insoluble phosphorus sources and soil. Folia Microbiol. 2021, 66, 69–77. [Google Scholar] [CrossRef] [PubMed]
- Li, H.; Jiang, J.; Liu, Z.; Lin, S.; Xia, G.; Xia, X.; Ding, B.; He, L.; Lu, Y.; She, Z. Peniphenones A-D from the mangrove fungus Penicillium dipodomyicola HN4-3A as inhibitors of Mycobacterium tuberculosis phosphatase MptpB. J. Nat. Prod. 2014, 77, 800–806. [Google Scholar] [CrossRef]
- Wu, L.; Yin, Z.; Fu, Y.; Yin, C. Biotransformation of major ginsenosides into compound K by a new Penicillium dipodomyicola strain isolated from the soil of wild ginseng. Afr. J. Biotechnol. 2012, 11, 15905–15915. [Google Scholar]
- Gaudin, K.; Ferey, L. Quality by Design: A tool for separation method development in pharmaceutical laboratories. LCGC Suppl. 2016, 29, 16–25. [Google Scholar]
- Abdelrahman, M.M.; Naguib, I.A.; Elsayed, M.A.; Zaazaa, H.A. Chromatographic Methods for Quantitative determination of ampicillin, dicloxacillin and their impurity 6-aminopenicillanic acid. J. Chromatogr. Sci. 2018, 56, 209–215. [Google Scholar] [CrossRef]
- Singh, V.; Haque, S.; Niwas, R.; Srivastava, A.; Pasupuleti, M.; Tripathi, C.K. Strategies for fermentation medium optimization: An in-depth review. Front. Microbiol. 2017, 7, 2087. [Google Scholar] [CrossRef]
- Nijland, J.G.; Ebbendorf, B.; Woszczynska, M.; Boer, R.; Bovenberg, R.A.; Driessen, A.J. Nonlinear biosynthetic gene cluster dose effect on penicillin production by Penicillium chrysogenum. Appl. Environ. Microbiol. 2010, 76, 7109–7115. [Google Scholar] [CrossRef]
- El-Marsafy, M.; Abdel-Akher, M.; El-Saied, H. Effect of media composition on the penicillin production. Zent. Bakteriol Parasitenkd Infekt. Hyg. 1977, 132, 117–122. [Google Scholar] [CrossRef]
- Cook, R.P.; Tulloch, W.J. The production of penicillin using fractions obtained from aqueous extracts of pea (Pisum sativum). Biochem. J. 1945, 39, 314–317. [Google Scholar] [CrossRef]
- Cook, R.P.; Brown, M.B. Effect of the source of nitrogen in the medium on the formation of penicillin by surface cultures of Penicillium notatum. Nature 1947, 159, 376. [Google Scholar] [CrossRef] [PubMed]
- Moyer, A.J.; Coghill, R.D. Penicillin: X. The effect of phenylacetic acid on penicillin production. J. Bacteriol. 1947, 53, 329–341. [Google Scholar] [CrossRef] [PubMed]
- Nagamune, T.; Endo, I.; Kato, N.; Nishimura, M.; Kobayashi, T. The effect of cultivation conditions on the penicillin production using a urethane foam-supported Penicillium chrysogenum. Bioprocess Eng. 1988, 3, 173–176. [Google Scholar] [CrossRef]
- Kumar, V.V.; Vigneshwaran, K.V.; Vasantharaj, J.; Isaac, P.; Bharathiraja, B. Optimization of sugarcane bagasse, nutrient and temperature on the yield of penicillin V in solid state fermentation by Penicillium chrysogenum. Int. J. Biotechnol. Biochem. 2010, 6, 477–483. [Google Scholar]
- Calam, C.T.; Driver, N.; Bowers, R.H. Studies in the production of penicillin, respiration and growth of Penicillium chrysogenum in submerged culture in relation to agitation and oxygen transfer. J. Appl. Chem. 1951, 1, 209–216. [Google Scholar] [CrossRef]
- Owen, S.P.; Johnson, M.J. The effect of temperature changes on the production of penicillin by Penicillium chrysogenum W49-133. Appl. Microbiol. 1955, 3, 375–379. [Google Scholar] [CrossRef] [PubMed]
- Asnaashari, M.; Ghanbary, M.A.T.; Tazick, Z. Optimization of penicillin G production by Penicillium chrysogenum. Ann. Biol. Res. 2013, 3, 5434–5440. [Google Scholar]
Disclaimer/Publisher’s Note: The statements, opinions and data contained in all publications are solely those of the individual author(s) and contributor(s) and not of MDPI and/or the editor(s). MDPI and/or the editor(s) disclaim responsibility for any injury to people or property resulting from any ideas, methods, instructions or products referred to in the content. |
© 2023 by the authors. Licensee MDPI, Basel, Switzerland. This article is an open access article distributed under the terms and conditions of the Creative Commons Attribution (CC BY) license (https://creativecommons.org/licenses/by/4.0/).